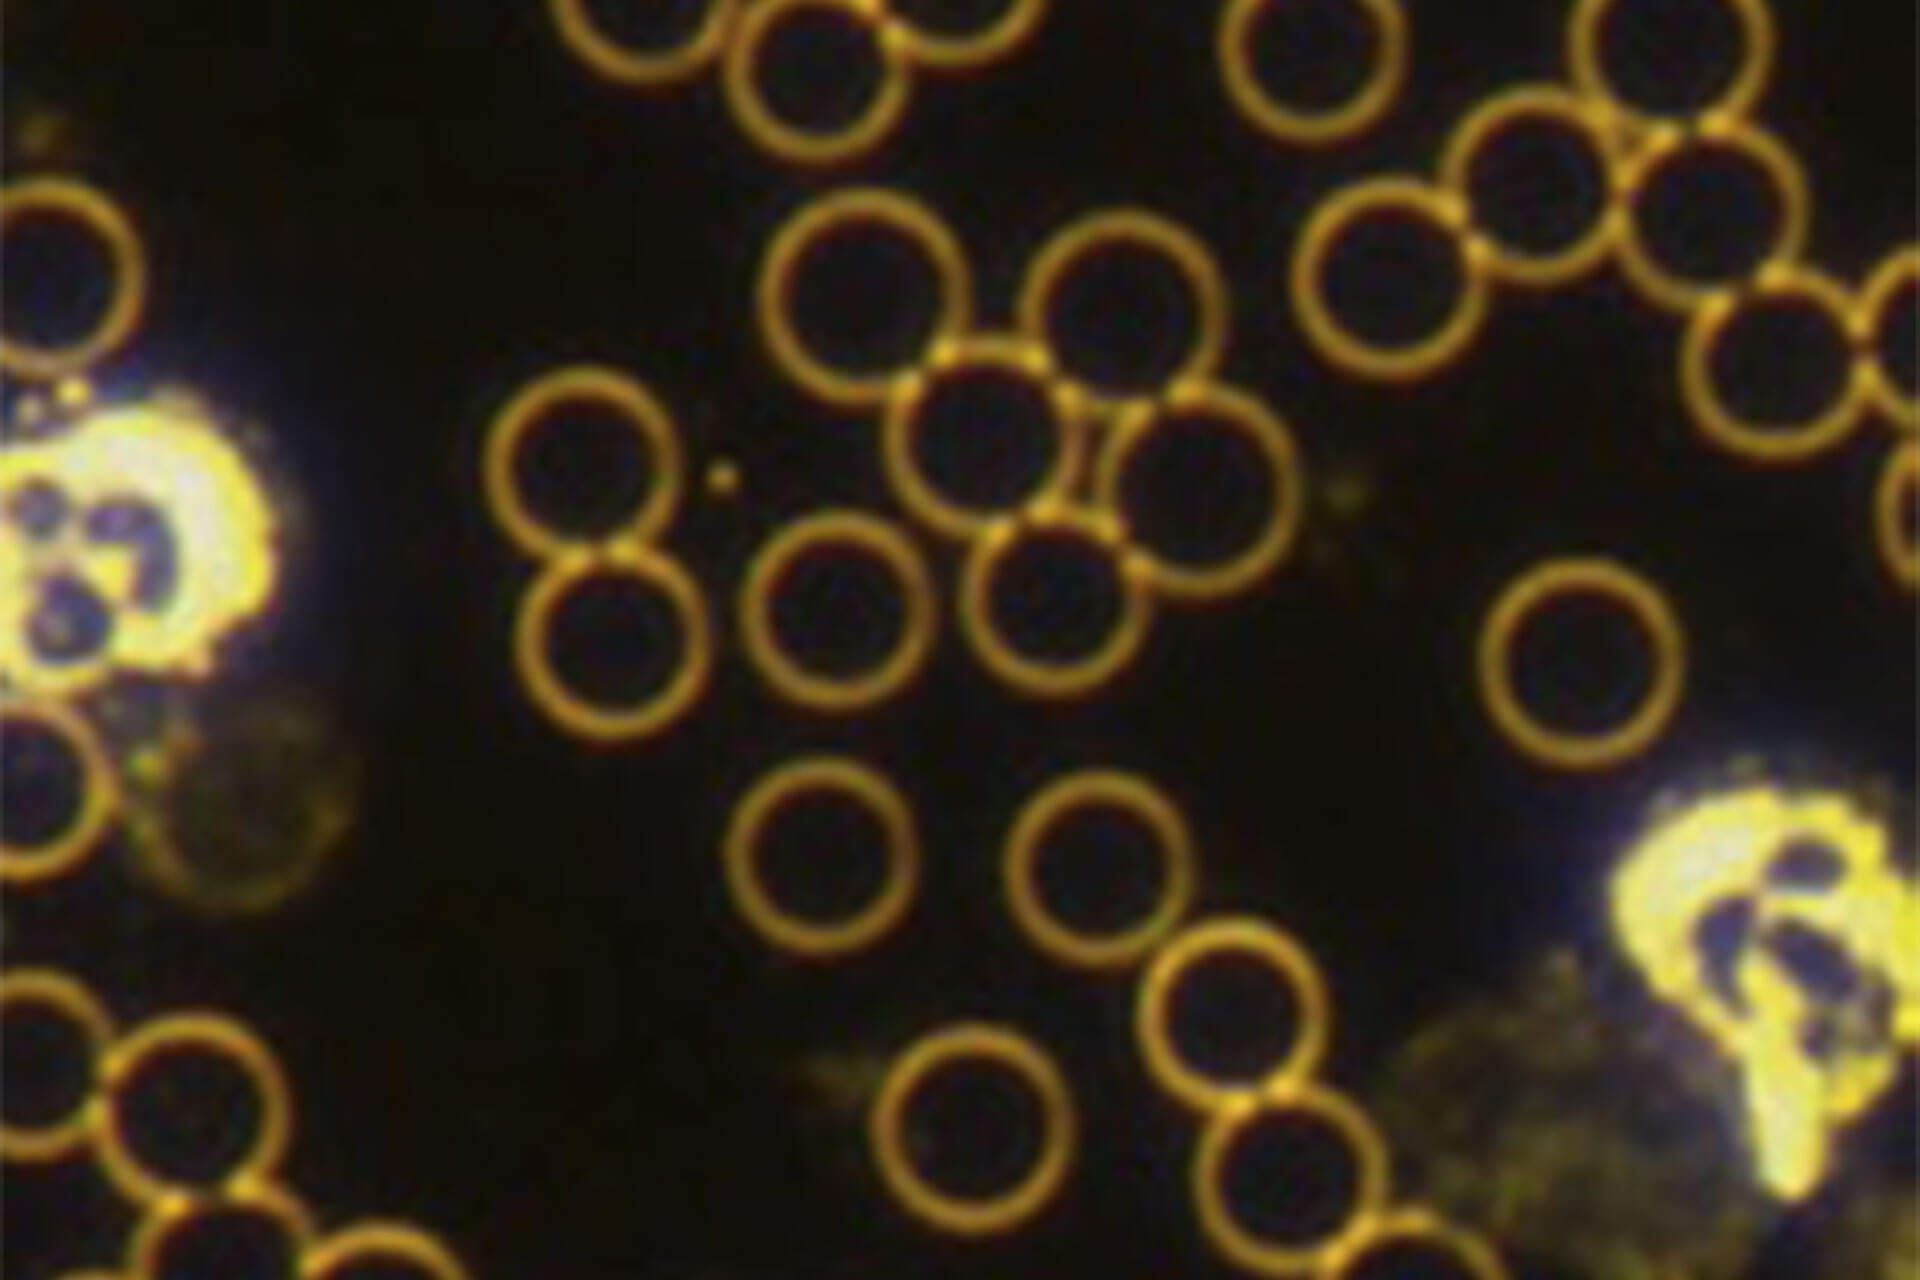

Kleinsche Felder verbessern die Bluteigenschaften:
Ergebnisse einer randomisierten, doppelblinden & placebokontrollierten Untersuchung
Unser Blut verrät viel über unseren Gesundheitszustand. Eine besondere Technik, das lebende Blut zu untersuchen, stellt die Dunkelfeld-Mikroskopie dar. Heilpraktiker Jörg Rinne, ein Spezialist auf diesem Gebiet, untersuchte unter Leitung des erfahrenen Heilpraktikers und Medical Coach Ralf Meyer mit einem solchen Mikroskop, welche Wirkung Kleinsche Felder auf das vitale Blut haben.
Die spezielle mikroskopische Technik ermöglichte es den Studienmachern das vitale Blut der 20 Probanden direkt zu betrachten. Dabei wurden lebende Blutproben untersucht, ohne sie vorher zu fixieren oder zu färben. Auf diese Weise kann die Struktur und die Zusammensetzung des Blutes in Echtzeit analysiert werden.
Für die randomisierte, doppelblinde und placebokontrollierte Anwendungsbeobachtung erhielten 20 Probanden eine Schlafmatte – 10 davon eine BioRelax Schlafmatte mit der Kleinsche Felder Technologie, 10 eine Placebomatte. Drei Monate schliefen die Probanden jede Nacht auf der Schlafmatte und wurden drei Mal zur Blutuntersuchung gebeten: vor, während (6 Wochen nach Beginn) und nach (12 Wochen nach Beginn) der Testphase.
Wissenswertes
Die Dunkelfeld-Mikroskopie erlaubt einen ganzheitlichen Blick auf das Blut. In ihrem natürlichen Zustand lassen sich die Zellen in ihrer Aktivität beurteilen - wie sie interagieren und ob es Auffälligkeiten gibt, die sich chemisch nicht so leicht messen lassen, wie die Aggregation der Thrombozyten oder Mikroentzündungen. Es ist also eine dynamische Betrachtung, die uns ein ganz anderes Bild vermittelt. Betrachtet werden in dieser Anwendungsbeobachtung:
- Entzündungsanzeichen
- Gesundheit der roten Blutkörperchen (Erythrozytengesundheit)
- Thrombozytenaggregation
- Harnsäurekristalle im Blut
- Leukozytenfunktion
- Membranstabilität /Leberstoffwechsel
- Hämatokritwert
- Oxidativer Stress
Bei einer klassischen Blutuntersuchung wird das Blut meist in einem Labor chemisch analysiert. Man erhält Werte wie den Hämoglobinspiegel, die Anzahl der roten und weißen Blutkörperchen oder andere Parameter. Diese sind natürlich wichtig, geben aber nur statische Informationen.
Zur Ermittlung, ob es einen sichtbaren Unterschied der Vitalblutparameter zwischen der Kontrollgruppe und der Gruppe mit der Kleinschen Felder Schlafmatte gibt, wurde die Summe aller Abweichungen der drei Untersuchungen bei allen Probanden erfasst und dargestellt. Ein hoher Gesamtwert bedeutet eine größere negativ zu bewertenden Abweichung vom Idealzustand. Je niedriger der Wert, desto besser der Gesundheitszustand nach Bewertung der Parameter der Vitalblutanalyse.
Alle Ergebnisse der Anwendungsbeobachtung finden Sie jetzt auch in der Ausgabe 06/2024 des Fachmagazins
"Die Naturheilkunde".
Zusammenfassung aller Messergebnisse
Besserer Gesundheitszustand durch Kleinsche Felder
Ob nach der Anwendung der Kleinschen Felder ein Unterschied in der Blutqualität sichtbar wurde, zeigt der Vergleich zwischen Kontroll- und Verumgruppe. Dabei wurden alle erfassten Vitalblutparameter der einzelnen Untersuchungen berücksichtigt. Diese Zusammenfassung lässt positive und signifikante Auswirkungen der Kleinsche Felder Schlafmatte auf den Gesundheitszustand des Blutes der Versuchsteilnehmer erkennen.

Versuchsgruppe mit Kleinsche Felder
Hier zeigte sich zunächst eine fast identische Ausgangslage im Vergleich zur Kontrollgruppe. Bereits nach 6 Wochen kam es jedoch zu einem signifikanten Unterschied: 21,6 % Besserung in der Verumgruppe zu 6 % Besserung in der Kontrollgruppe. Der durchschnittliche Gesundheitszustand, gemessen an den Vitalblutparametern, verbesserte sich signifikant. Diese positive Veränderung baute sich nach 12 Wochen Anwendung auf 37 % im Vergleich zur Kontrollgruppe (6 %) aus.

Versuchsgruppe ohne Kleinsche Felder
Vor der Anwendung der Placebomatte wiesen die Probanden einen Gesamtpunktewert von 21,6 auf. Dieser fiel bei der zweiten Untersuchung nach 6 Wochen leicht ab auf einen Wert von 20,3 und blieb dann bis zur Abschlussuntersuchung nach 12 Wochen Anwendung konstant.
Erste Hinweise auf eine systemische Wirkung
Reduktion von Entzündungsreaktionen
Während akute Entzündungen oft nützlich und notwendig sind, können chronische Entzündungen zu gesundheitlichen Problemen führen, wenn sie übermäßig stark ausfallen oder sich gegen gesundes Gewebe richten. Unter der Anwendung der Kleinsche Felder kam es bei den Probanden zu einer hochsignifikanten Verminderung von entzündlichen Prozessen. Bereits 6 Wochen nach Beginn der Anwendung hatten sich die Entzündungszeichen im Dunkelfeld-Mikroskop um 13,6 % reduziert und nach 12 Wochen Anwendung um 48,9 %.

Vitalblutanalyse zeigt frühzeitige Veränderungen
Entzündungsanzeichen werden im Vitalblut sichtbar
Im Dunkelfeld-Mikroskop können verschiedene Veränderungen im Vitalblut auf eine erhöhte Entzündungsaktivität hindeuten:
- Verklumpung der roten Blutkörperchen: Dies kann auf eine erhöhte Entzündungsaktivität hinweisen.
- Veränderungen in der Form und Struktur der Blutzellen: Entzündungen können die Form der Erythrozyten verändern.
- Erhöhte Anzahl von weißen Blutkörperchen: Dies ist ein typisches Zeichen für eine Immunreaktion auf Entzündungen.
- Anwesenheit von Zelltrümmern und Mikroorganismen: Diese können auf eine Infektion oder Entzündung hinweisen.
Reduzierte Thrombozytenaggregation nachweisbar
Blutplättchen ballen sich weniger zusammen
In der Anwendergruppe mit Kleinsche Felder kam es erst zu einer Erhöhung um 7,1 % und nach weiteren 6 Wochen zu einem signifikanten Abfall der Thrombozytenaktivität und somit weniger Tendenz der Zusammenballung der Thrombozyten (Blutplättchen) um 50 %. Parallel hierzu konnte man im selben Zeitraum anhand der Leukozyten (weiße Blutkörperchen) eine Reduktion der Entzündungsreaktion um 50 % nach 12 Wochen sehen, womit sich diese beiden Aussagen gegenseitig verstärken.


Thrombozyten im Dunkelfeld-Mikroskop
Thrombozyten reagieren zeitversetzt
Die Thrombozytenaggregation ist der Prozess, bei dem Blutplättchen (Thrombozyten) zusammenkleben und so ein Blutgerinnsel bilden können. Die Anzahl an Thrombozyten steigt bei entzündlichen Prozessen an und mit ihnen auch die Tendenz einer Zusammenballung. In der Dunkelfeld-Mikroskopie erkennt man eine derartige pathologische Zusammenballung der Thrombozyten. Wenn die Entzündung abklingt, sieht man dies relativ früh an der Abnahme der Leukozyten (weiße Blutkörperchen). Die Thrombozytenanzahl vermindert sich zeitversetzt und somit verlangsamt.
Rückgang der Erythrozytenpathologie
Verbesserter Aufbau und Vitalität der roten Blutkörperchen
Viele Parameter haben Einfluss auf die Blutbildung und damit auf den Aufbau und die Stabilität der roten Blutkörperchen (Erythrozyten). Bei den Anwendern der Kleinschen Felder kam es zu einer hochsignifikanten Optimierung dieser Faktoren um 47,4 % nach 6 Wochen der Anwendung und nach 12 Wochen um 57,9 %. Es waren signifikant weniger pathologische Veränderungen nach drei Monaten der Anwendung im Blut zu sehen. Eine Verbesserung der Pathologie der roten Blutkörperchen kann wiederum zu einer besseren Sauerstofftransportfähigkeit des Blutes führen, was in vielen Bereichen des Körpers entscheidend sein kann.


Funktionen der roten Blutkörperchen für die Gesundheit
Rote Blutkörperchen haben mehr als eine wichtige Aufgabe
Rote Blutkörperchen, auch Erythrozyten genannt, haben mehrere wichtige Aufgaben im Körper:
- Sauerstofftransport: Sie transportieren Sauerstoff von den Lungen zu den Geweben und Organen.
- Kohlendioxidtransport: Sie bringen Kohlendioxid von den Geweben zurück zu den Lungen, wo es ausgeatmet wird.
- pH-Wert-Regulation: Sie helfen, den pH-Wert des Blutes zu regulieren, indem sie überschüssige Säuren und Basen aufnehmen und abgeben.
Diese Funktionen sind entscheidend für das Überleben und die Gesundheit des Körpers. Ohne ausreichend rote Blutkörperchen kann der Körper nicht effizient arbeiten und es kann zu Müdigkeit und anderen gesundheitlichen Problemen kommen.
Verbesserte Harnsäurekonzentration im Vitalblut nachweisbar
Weniger Harnsäurekristalle im Blut
Eine signifikante Verbesserung der Harnsäurekonzentration im Blut und somit des Abbaus und der Ausscheidung der Harnsäure konnte bei den Teilnehmern der Verumgruppe der Kleinsche Felder Technologie beobachtet werden. Bereits nach den ersten sechs Wochen der Anwendung waren 23,0 % weniger Harnsäurekristalle im Blut sichtbar. Dieser Effekt steigerte sich auch nach weiteren sechs Wochen der Anwendung auf eine Reduktion der Harnsäurekristalle von 30,7 %.


Harnsäurekristalle im Dunkelfeld-Mikroskop
Ungleichgewicht zwischen Entstehung und Ausscheidung vermeiden
Im menschlichen Organismus werden jeden Tag große Mengen von Zellen neu gebildet und überalterte Zellen abgebaut. Die dabei anfallende Harnsäure wird überwiegend über die Nieren, aber auch über die Haut (Schweiß), den Speichel und die intestinale Sekretion ausgeschieden. Wenn jedoch ein Ungleichgewicht zwischen Entstehung und Ausscheidung der Harnsäure besteht, kann die Harnsäure in Form von lichtbrechenden Kristallen im Blut ausfallen. Wenn langfristig ein erhöhter Harnsäurewert vorliegt kann dies zu Gicht führen.
Vitalblut zeigt bessere Fließeigenschaften
Verminderung der Geldrollenbildung
Bei den Anwendern der Kleinsche Felder Technologie kam es in den ersten sechs Wochen zu einer Verminderung der Geldrollenbildung um 38,9 % und nach 12 Wochen um 16,7 % vom Ausgangswert, was sich positiv auf den Blutfluss auswirken kann.


Hämatokrit im Dunkelfeld-Mikroskop
Was ist die Geldrollenbildung?
Bei einer Geldrollenbildung liegen die roten Blutkörperchen unter dem Mikroskop dicht aneinander - wie die Münzen in einer Geldrolle. Begünstigt wird die Zusammenballung der roten Blutkörperchen, wenn der Hämatokritwert vom Ideal abweicht. Hierbei handelt es sich um den prozentualen Anteil zellulärer Elemente am gesamten Blutvolumen. Die Normwerte liegen im tabellarischen Blutbild bei ca. 40 – 50 % Blutzellen, wobei davon 96 % die roten Blutkörperchen ausmachen (Erythrozyten). Bereits bei geringen Abweichungen können im Kapillarblut die "Geldrollen" entstehen und zu Durchblutungsstörungen führen.
Sichtbarer Rückgang der freien Radikalauswirkung
Weniger oxidativer Stress
Unter der Anwendung der Kleinsche Felder Technologie kam es zu einem deutlichen Rückgang der freien Radikalauswirkung innerhalb der untersuchten Blutproben um 28,6 % nach 6 Wochen und 14,3 % nach 12 Wochen.


Freie Radikale können Zellen schädigen
Was ist oxidativer Stress?
Oxidativer Stress entsteht, wenn es in unserem Körper ein Ungleichgewicht zwischen schädlichen Molekülen, sogenannten freien Radikalen, und den Abwehrmechanismen gibt, die diese neutralisieren sollen. Freie Radikale können Zellen und Gewebe schädigen, was zu verschiedenen Krankheiten und Alterungsprozessen führen kann. Normalerweise hat unser Körper Antioxidantien, die helfen, diese freien Radikale zu bekämpfen, aber wenn es zu viele freie Radikale gibt, spricht man von oxidativem Stress.
Deutlich stärkere "Zellhülle" nachweisbar
Stabilere Membran der roten Blutkörperchen
Bei den Anwendern der Kleinsche Felder Technologie kam es nach sechs Wochen zu einer Stabilisierung der Membranen der roten Blutkörperchen um 32,0 % und nach 12 Wochen um 44,0 %.


Membranstabilität in der Dunkelfeld-Mikroskopie
Was sagt die Membranstabilität aus?
Die Membranstabilität bezieht sich auf die Fähigkeit der Zellmembran, ihre Struktur und Funktion unter verschiedenen Bedingungen aufrechtzuerhalten. In der Dunkelfeld-Mikroskopie kann man sehen, wie gut die Zellmembran intakt bleibt und funktioniert. Wenn die Membranstabilität hoch ist, bedeutet das, dass die Zellen gesund sind und ihre Membranen nicht leicht beschädigt werden. Wenn die Membranstabilität niedrig ist, können die Zellen anfälliger für Schäden und Funktionsstörungen sein.
Zusätzlich wurden zwei Fallbeispiele dokumentiert:
- Eine Teilnehmerin berichtet über die Reduktion von geschwollenen Beinen: Seit Anwendung der Kleinsche Felder Schlafmatte kam es zu einer signifikanter Abnahme tagsüber angeschwollener Beine.
- Zudem hatte die Teilnehmerin zuvor 5-6 Krämpfe pro Nacht. Durch das Schlafen auf Kleinsche Felder reduzierten sich die Krämpfe auf 1-2 pro Nacht. Dadurch verbesserte sich das Einschlafen, weil sie keine “Angst vor Krämpfen mehr" hatte. Auch das Durchschlafen besserte sich.
- Ein weiterer Teilnehmer mit der Schlafmatte berichtete, dass er schneller einschläft, besser durchschläft, er sich besser konzentrieren kann und sich die Gelenkschmerzen signifikant verbessert haben.
Ergebnisse der Anwendungsbeobachtung im Überblick
Die Ergebnisse der Anwendungsbeobachtung geben erste Hinweise darauf, dass Kleinsche Felder einen positiven Einfluss auf den allgemeinen Gesundheitszustand haben können. Alle vitalen Blutparameter zeigten nach 12-wöchiger Anwendung der Kleinsche Felder eine Verbesserung im Dunkelfeld-Mikroskop. Dies könnte eine bedeutende Rolle für die Prävention und Linderung von Beschwerden spielen.
Nach den hier vorliegenden Ergebnissen und Patientenberichten sprechen die Autoren der Kleinsche Felder Technologie in der Prävention, Aufrechterhaltung der Gesundheit und als Therapiebegleitung bei der Behandlung von Mikrozirkulationsstörungen, chronischen Entzündungen, Stoffwechselstörungen, chronischen Schmerzen, Schlafstörungen und Energiemangelzuständen eindeutig eine Anwendungsempfehlung aus.
Hat die Vorstudie Relevanz für den Alltag?
Unser Fazit der Vorstudie
Die untersuchten Vitalblutparameter lassen erste Rückschlüsse auf die allgemeine Gesundheit zu und auch welche Rolle die Anwendung der Kleinschen Felder bei chronischen Erkrankungen, Zellalterung und Stoffwechselstörungen spielen könnten:
Ob die roten Blutkörperchen optimal geformt sind, sich die Blutplättchen pathologisch verklumpen oder Entzündungen bestehen, hat Einfluss auf die Durchblutung und vor allem auf die Mikrozirkulation. Eine Verbesserung dieser Parameter kann sich daher positiv auf die Fließeigenschaften des Blutes auswirken.
Gesunde rote Blutkörperchen sind für viele lebenswichtige Funktionen im Körper unerlässlich: Ohne gesunde Erythrozyten würde unser Körper nicht ausreichend mit Sauerstoff versorgt werden. Eine ausreichende Anzahl gesunder roter Blutkörperchen ist notwendig, um Müdigkeit und Schwäche zu vermeiden und die körperliche Leistungsfähigkeit zu erhalten.
Insbesondere chronische Entzündungen können den Körper belasten und langfristig Organe und Gewebe schädigen. Häufig sind sie mit Beschwerden wie Herzkrankheiten, Diabetes und Durchblutungsstörungen verbunden. Eine Reduzierung der Entzündungsanzeichen kann daher die Lebensqualität und Leistungsfähigkeit in vielen Bereichen verbessern.








